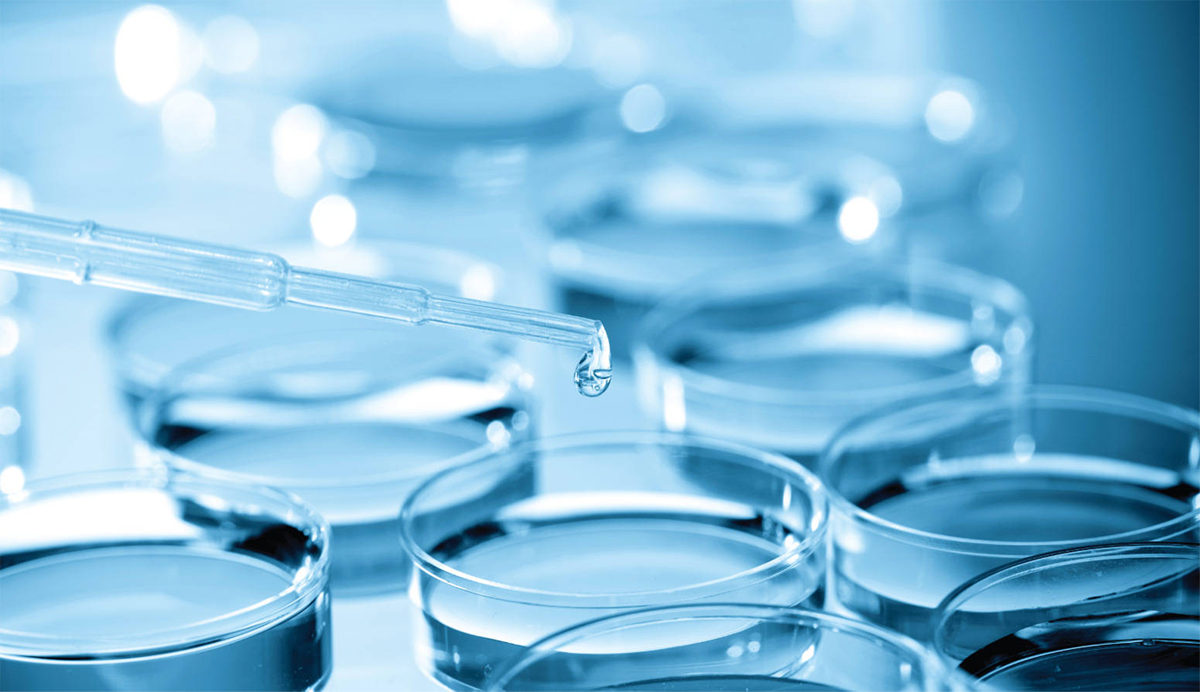

TSB液體培養(yǎng)基的配方優(yōu)化與微生物生長(zhǎng)調(diào)控
1、什么是培養(yǎng)皿?
培養(yǎng)皿是一種用于微生物或細(xì)胞培養(yǎng)的實(shí)驗(yàn)室器皿,它由一個(gè)圓盤狀的底和一個(gè)蓋組成,基本用玻璃或塑料制成。玻璃的多用于植物材料、微生物培養(yǎng)和動(dòng)物細(xì)胞的貼壁培養(yǎng)。塑料的大多數(shù)是聚乙烯材料的,有一次性的和多次使用的,適合實(shí)驗(yàn)室的接種、劃線、分離細(xì)菌的操作,可以用于植物材料的培養(yǎng)。
2.培養(yǎng)皿是怎么來(lái)的?
1887年,一位名叫Julius Richard Petri的德國(guó)科學(xué)家開發(fā)了一種淺層嵌套盤,用于實(shí)驗(yàn)室的實(shí)驗(yàn)。在培養(yǎng)皿被發(fā)明之前,科學(xué)家使用的是試管,空酒瓶和其他類型的玻璃罐培養(yǎng)培養(yǎng)物。與這些玻璃容器不同,培養(yǎng)皿的蓋子牢固地蓋在培養(yǎng)皿上,可以很好的保護(hù)內(nèi)部培養(yǎng)物。
3.培養(yǎng)皿在實(shí)驗(yàn)室中扮演了什么角色?
鑒于培養(yǎng)皿多功能的特性,它們是實(shí)驗(yàn)室中最常見的設(shè)備之一。它不僅為細(xì)菌,酵母,霉菌和病毒的生長(zhǎng)提供了絕佳的環(huán)境,而且還有其他的用途。它們還可以用來(lái)觀察昆蟲的行為,觀察種子的發(fā)芽,存儲(chǔ)樣品并蒸發(fā)溶劑。
4.培養(yǎng)皿在歷史中起到了什么重要作用?
培養(yǎng)皿是20世紀(jì)最重要的發(fā)現(xiàn)之一,其中最廣為人知的就是青霉素的發(fā)現(xiàn)。
亞歷山大·弗萊明(Alexander Fleming),倫敦圣瑪麗醫(yī)院工作的細(xì)菌學(xué)教授,因1928年發(fā)現(xiàn)青霉素而廣受贊譽(yù)。